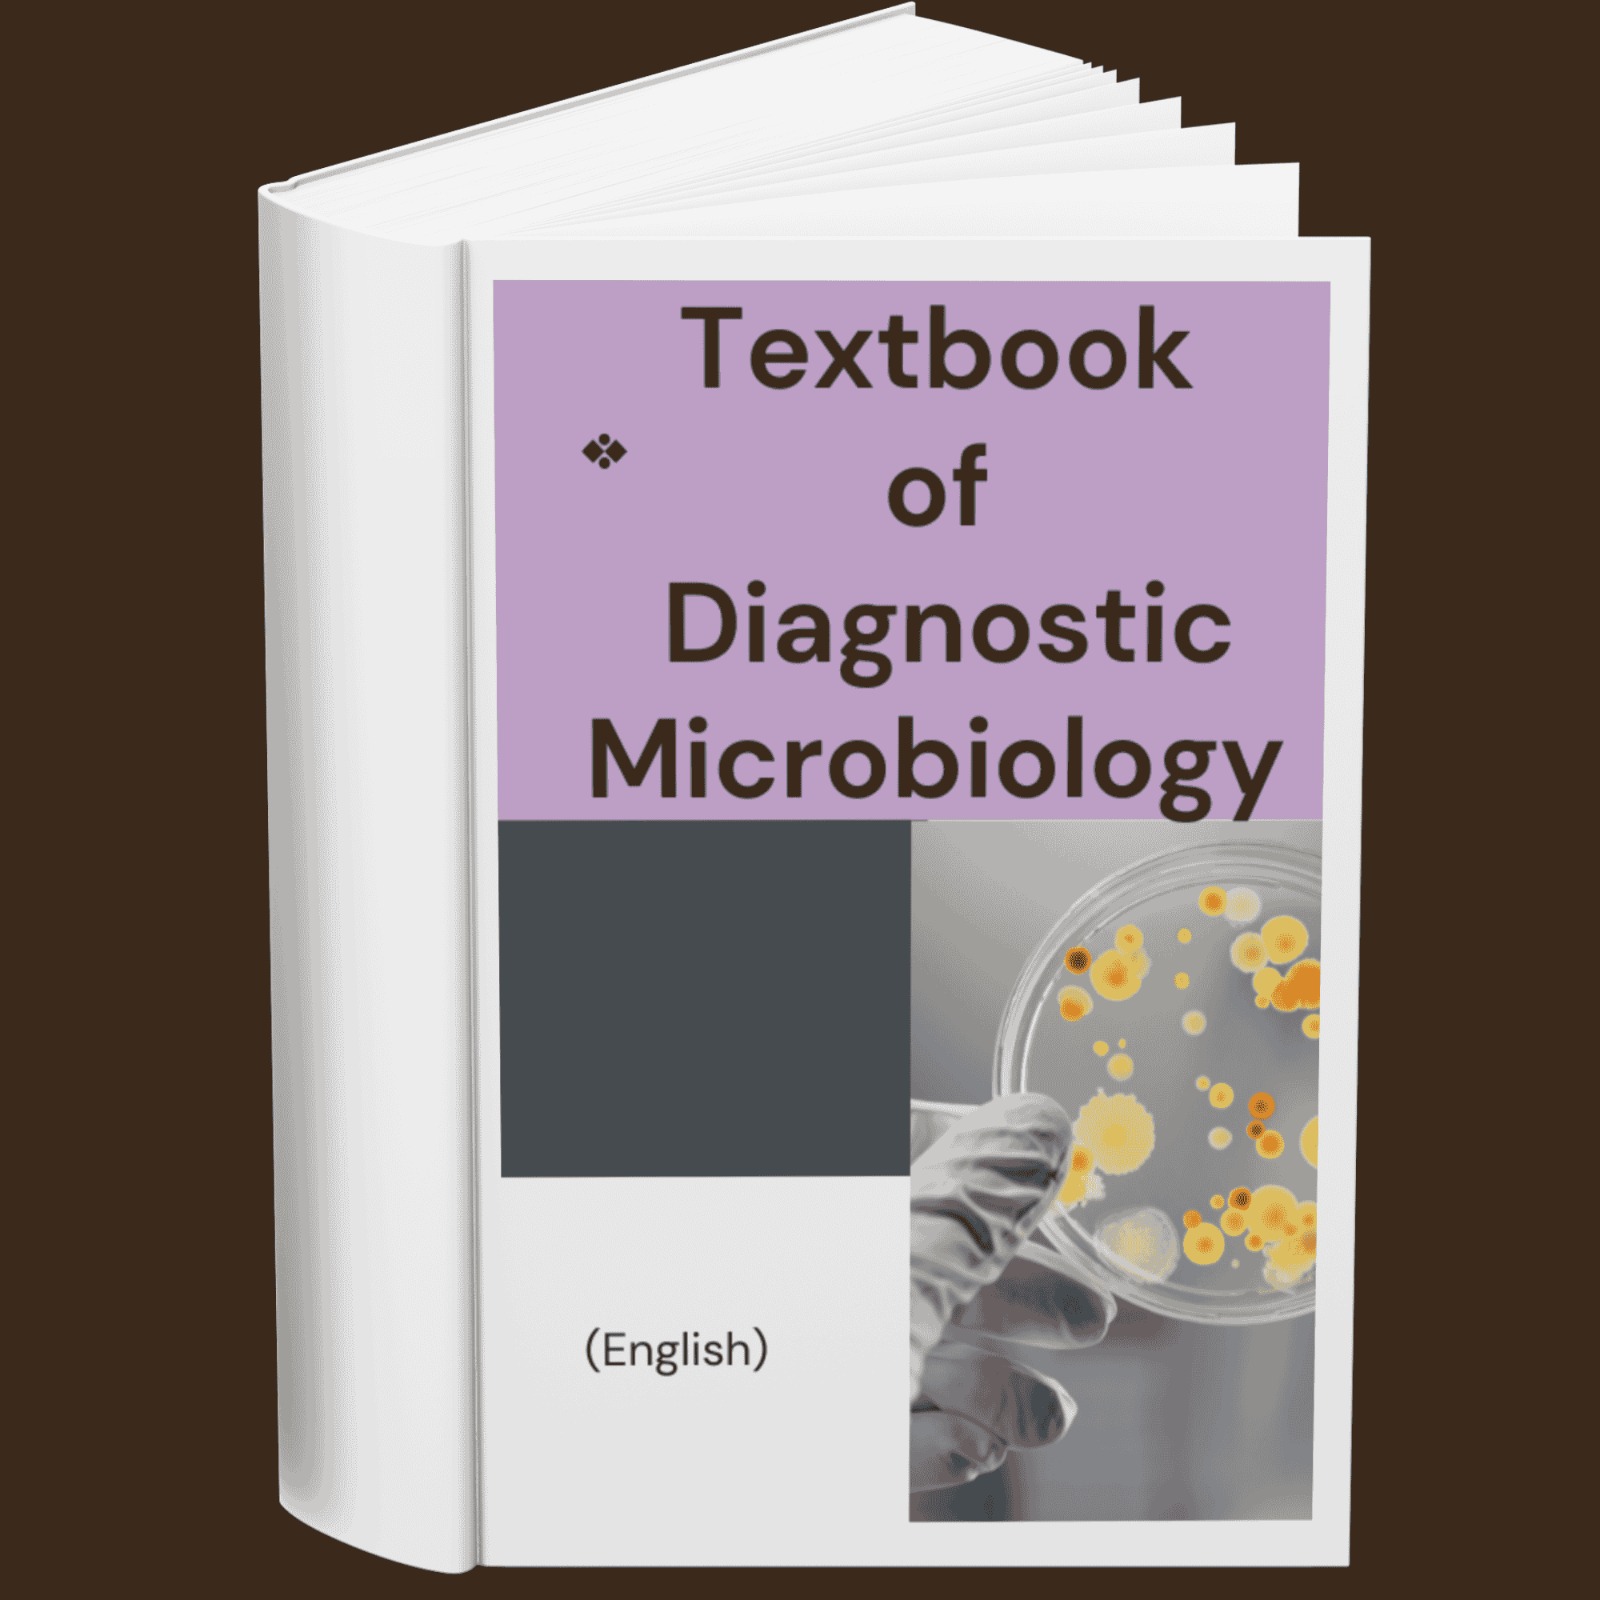
Textbook of Diagnostic Microbiology (English)

Description
The Textbook of Diagnostic Microbiology is a detailed and authoritative guide for microbiologists, clinical laboratory professionals, and healthcare providers seeking in-depth knowledge on the identification, analysis, and diagnosis of infectious diseases. This comprehensive text covers bacteriology, mycology, virology, and parasitology, providing detailed methods for isolating and identifying pathogens. From laboratory techniques to case studies and diagnostic algorithms, this eBook is an indispensable resource for anyone involved in the field of diagnostic microbiology.
You Will Learn
- Techniques for isolating and identifying microbial pathogens.
- Diagnostic algorithms for infectious diseases.
- How to handle bacteriology, virology, mycology, and parasitology in clinical settings.
- Key methods for identifying emerging infectious diseases.
- Best practices for diagnostic microbiology laboratories.
Specification: Textbook of Diagnostic Microbiology (English)
|
20 reviews for Textbook of Diagnostic Microbiology (English)
Show all
Most Helpful
Highest Rating
Lowest Rating
Add a review

Textbook of Diagnostic Microbiology (English)
Original price was: $3.60.$0.36Current price is: $0.36.

Dr. Ishaan Prasad –
A great book for beginners as well as experienced microbiologists. Covers classical and modern diagnostic techniques comprehensively.
Rahul Khanna –
Very useful for microbiology students. The practical examples and laboratory techniques are explained step by step.
Dr. Kavita Pillai –
A well-detailed book that provides a thorough understanding of diagnostic microbiology. The practical aspects are particularly well covered.
Saurabh Mishra –
Perfect for medical students and professionals working in diagnostic labs. The updated edition includes the latest advancements in microbiology.
Tanya Ghosh –
A valuable resource for students and lab professionals. The book’s logical flow enhances understanding of key microbiology concepts.
Dr. Abhishek Banerjee –
One of the best books on microbiology diagnostics. The explanation of culture techniques and biochemical tests is excellent.
Siddharth Desai –
A must-read for microbiologists! Covers all major diagnostic techniques, from traditional methods to molecular approaches.
Ritika Sharma –
Very well-explained concepts with practical insights. Ideal for those preparing for exams and working in diagnostic labs.
Dr. Manish Trivedi –
A reliable reference book for diagnostic microbiology. The case studies and real-world applications make it highly engaging.
Dr. Anjali Saxena –
Extremely useful for medical students and laboratory professionals. The book is written in a simple yet informative manner
Dr. Kunal Rao –
A practical and user-friendly book. The recent updates on molecular diagnostic techniques are very informative.
Sneha Joshi –
Provides an excellent foundation in diagnostic microbiology. Covers everything from specimen collection to advanced identification techniques.
Rakesh Iyer –
This book simplifies complex microbiological techniques. The quality of images and diagrams is outstanding.
Neha Deshmukh –
Highly recommended for medical and paramedical students. The clinical correlations help in better understanding of disease mechanisms.
Arvind Patel –
An excellent resource for laboratory diagnosis of infectious diseases. The step-by-step methods are very helpful.
Simran Kaur –
A well-written and easy-to-understand book. Ideal for postgraduate students and professionals working in microbiology labs.
Rajeev Nair –
This book provides in-depth knowledge of diagnostic microbiology. The inclusion of recent advancements is highly beneficial.
Sandeep Kulkarni –
A must-have for microbiology students! Covers both theoretical and practical aspects of microbial identification with great clarity.
Priya Iyer –
This book is an excellent guide for understanding microbial diagnostics. The case-based approach makes learning easier and more practical.
Akash Menon –
A comprehensive and well-structured book covering all essential aspects of diagnostic microbiology. Perfect for medical students and lab professionals.